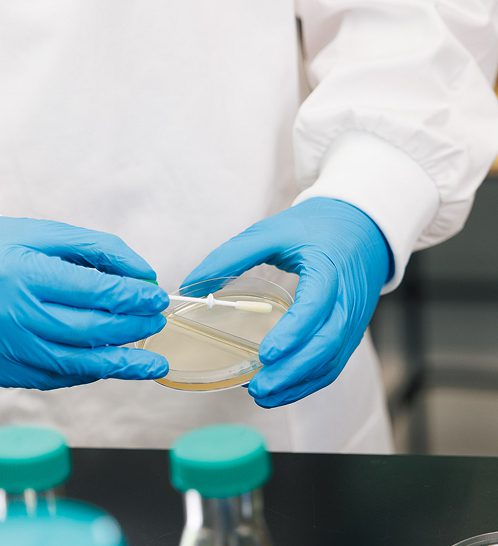
Screenshot
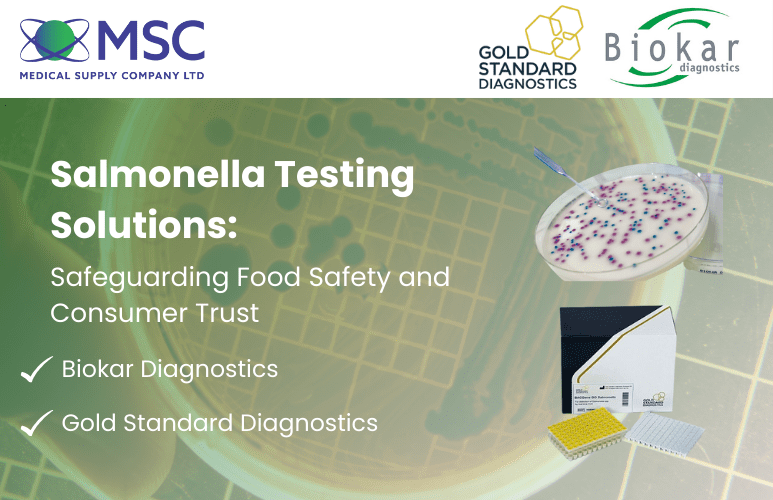
Salmonella Testing Solutions

Welcome to MSC
Enabling Science,
Supporting Progress
Trusted laboratory and diagnostic solutions for over fifty years
Welcome to MSC
Extending Service
Beyond Supply
Quality, care and integrity from installation to ongoing support
Welcome to MSC
Innovating Healthcare
Through Data
Smart Health Informatics tailored to the Irish healthcare market
Our Approach
We deliver innovative, cutting-edge diagnostics, engineering and health informatics so that the healthcare and research communities can stay prepared, protected and performing at their best.
Our STORY
About MSC
We’re a 100% Irish-owned business, and our solutions have been trusted across the diagnostics, life sciences, health informatics and engineering industries for six decades. Our dedicated team backed by our industry-leading partners delivers quality, leading-edge equipment, expertise and services to organisations all over Ireland and Northern Ireland.
MSC’s engineering solutions keep laboratories running efficiently through our dedicated calibration, maintenance and validation services. Transforming clinical data into actionable insights also enables our customers to create flexible, locally-supported digital health solutions that improve patient outcomes.
Learn about our journey, our team and how we support science across Ireland.
Our PRODUCT RANGE
Featured Products

WHAT WE DO
Services
Our full suite of professional services is designed to support laboratories, hospitals and research facilities across Ireland. From expert equipment installation and ISO-accredited calibration to clean air solutions, temperature mapping and cutting-edge health informatics, our experienced team ensures your operations remain compliant, efficient and future-ready.
Explore how we support Irish science and healthcare
through our trusted service.



INSIGHTS & NEWS
Recent News
BRANDS
Who We Represent

























Client Testimonials
-
We purchased a GloveFast Cyto Pharma Isolator from MSC in 2023. We were extremely happy with the service provided by MSC from the pre-purchase advice, to the pre-installation site visits and feedback, to the actual installation and now post-installation servicing and maintenance. I would and have recommended MSC to other pharmacists.
Katie Cooke
Cork University Hospital
-
We have purchased several large pieces of laboratory equipment from MSC over the last two years. We have found them very helpful and professional. We have also used their service options for our equipment. All their staff have been knowledgeable and fast to answer any queries.
Finola Cliffe
Hooke Bio Ltd
-
We’ve been very impressed with MSC’s service, from initial consultation to installation and after-sales support. Their team ensured a smooth installation of safety cabinets, and their efficient temperature mapping services helped us meet regulatory compliance.
Alma Clancy & Fergus Guilfoyle
Coombe Women & Infants University Hospital
-
Our Octa was installed on 6th December 2023 by Michael Burke and Sara Jane, who ensured the instrument was positioned correctly and fully calibrated for HbA1c testing the same day. The process was efficient, with the system ready for patient samples within hours. Follow-up training was clear and well delivered, and any subsequent issues were resolved quickly by a knowledgeable support team.
Barry O’Dea
Beacon Hospital
-
I have had nothing but a wonderful positive professional and efficient experience with MSC from the moment I initially met Cian to the project’s completion. A special mention to the amazing Engineers, Gary O Sullivan, Gary Doran and Keith Tuffin, who’s professional and’ hassle free’ approach to every detail of planning through to execution is commendable and of the highest standard
Sarah Toner
Galway Clinic
-
MSC delivered beyond our expectations. We set tight deadlines, and the fume hood installation was completed promptly without any disruptions to our operations. I am thoroughly impressed with the quality of work provided by MSC, and their commitment to meeting our project’s needs surpassed our expectations. I highly recommend MSC for any fume hood installation or similar projects and endorse MSC as a valuable and reliable partner.
Andrew Morrisey
Atlantic Technology University Galway